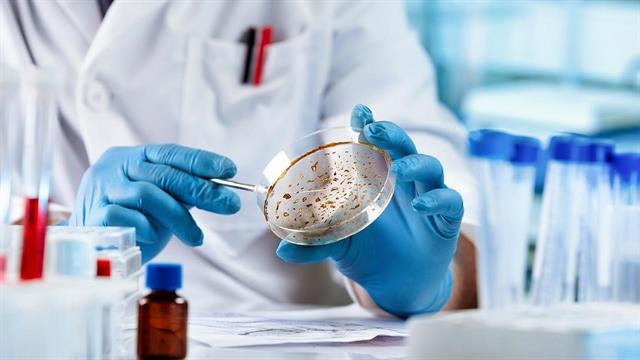
Με αρχαίο DNA, επιστήμονες χαρτογράφησαν 37.000 χρόνια ασθενειών στην Ευρώπη και την Ασία

Οι ζωονόσοι - ασθένειες που μεταδίδονται από τα ζώα στους ανθρώπους - άρχισαν να κερδίζουν έδαφος πριν από περίπου 6.500 χρόνια με την άνοδο της κτηνοτροφίας, σύμφωνα με νέα μελέτη.
Από τη γρίπη των πτηνών έως τον ιό Ζίκα, περισσότερες από 200 σύγχρονες ασθένειες ταξινομούνται ως ζωονόσοι, δηλαδή αυτές που μπορούν να μεταδοθούν στον άνθρωπο μέσω ζώων.
Eυρέως διαδεδομένες οι ζωονόσοι, βρίσκονται συχνά στο επίκεντρο σύγχρονων κρουσμάτων, επιδημιών και έρευνας. Έξι στις δέκα γνωστές μολυσματικές ασθένειες είναι ζωονόσοι και τρεις στις τέσσερις νέες ή αναδυόμενες ασθένειες που επηρεάζουν τους ανθρώπους προέρχονται από ζώα.
Οι επιστήμονες, εδώ και καιρό εικάζουν ότι αυτές οι ασθένειες άρχισαν να πλήττουν σοβαρά τις κοινωνίες περίπου την εποχή που εξημερώθηκαν τα ζώα, αν και ποτέ δεν είχαν τα γενετικά στοιχεία ούτε είχαν προσδιορίσει ένα συγκεκριμένο χρονοδιάγραμμαμέχρι τώρα.
Σε μια νέα μελέτη που δημοσιεύθηκε πρόσφατα στο περιοδικό Nature, μια ομάδα επιστημόνων εντόπισε τη γενετική ιστορία 214 ασθενειών σε όλη την Ευρώπη και την Ασία τα τελευταία 37.000 χρόνια.
Οι ερευνητές διαπίστωσαν ότι οι ζωονόσοι εμφανίστηκαν πριν από περίπου 6.500 χρόνια και κορυφώθηκαν πριν από 5.000 χρόνια. Αυτό τους εξέπληξε, επειδή ήταν αρκετές χιλιάδες χρόνια αφότου οι άνθρωποι στη Μεσοποταμία και τη Νοτιοανατολική Ασία άρχισαν να εξημερώνουν ζώα. Ωστόσο, τα γενετικά στοιχεία δείχνουν ότι οι ζωονόσοι αρχικά έγιναν διαδεδομένες στην Ασία και τη Ρωσία, καθώς οι κοινότητες μεταπήδησαν από τον τρόπο ζωής των κυνηγών-τροφοσυλλεκτών σε νομαδική κτηνοτροφία ή γεωργία.
Έχοντας ήδη εξημερώσει τα άλογα, οι κτηνοτροφικές κοινότητες άρχισαν να ταξιδεύουν με άμαξες που έσερναν βόδια, επιτρέποντάς τους να ταξιδεύουν μακρύτερα και να ανταλλάσσουν αγαθά, ιδέες και ασθένειες με άλλες νομαδικές κοινότητες. Αν και ορισμένα παθογόνα πιθανότατα μεταδόθηκαν από τα ζώα στους ανθρώπους ακόμη νωρίτερα, αυτές οι αλλαγές έκαναν την εξάπλωση πιο διαδεδομένη, σύμφωνα με την έρευνα.
Μια εκτεταμένη ανάλυση DNA από αρχαία ανθρώπινα λείψανα κατέστησε δυνατή τη συγγραφή αυτού του χρονικού. Οι ερευνητές εξήγαγαν τα υπολείμματα μικροβιακού γενετικού υλικού από τα δόντια και τα οστά 1.313 ανθρώπινων σκελετών και ταυτοποίησαν 5.486 αλληλουχίες DNA από βακτήρια, παράσιτα και ιούς. Πολλά από αυτά τα λείψανα βρέθηκαν στους ίδιους τάφους, γεγονός που υποδηλώνει ότι ένα μόνο συμβάν μετάδοσης σκότωσε πολλούς ανθρώπους.
Μεταλλάξεις
Ωστόσο, η μελέτη έδειξε ότι με την πάροδο του χρόνου, οι μεταλλάξεις σε αυτά τα παθογόνα βοήθησαν στην ενίσχυση του ανοσοποιητικού συστήματος των νομάδων ενώ οι μη μετακινούμενοι αγρότες και κυνηγοί-τροφοσυλλέκτες υπέκυψαν στις νέες ασθένειες. Από την άλλη πλευρά, όπως έδειξε μια μελέτη πέρυσι, το εξελισσόμενο ανοσοποιητικό σύστημα αυτών των νομάδων μπορεί επίσης να τους έχει κάνει ευάλωτους σε χρόνιες ασθένειες, συμπεριλαμβανομένης της σκλήρυνσης κατά πλάκας.
«Μεταλλάξεις που ήταν επιτυχημένες στο παρελθόν είναι πιθανό να επανεμφανιστούν», δήλωσε ο Eske Willerslev, εξελικτικός γενετιστής στο Πανεπιστήμιο της Κοπεγχάγης και κύριος συγγραφέας τόσο της νέας μελέτης όσο και της περσινής δημοσίευσης. «Αυτή η γνώση είναι σημαντική για τα μελλοντικά εμβόλια, καθώς μας επιτρέπει να ελέγξουμε εάν τα τρέχοντα εμβόλια παρέχουν επαρκή κάλυψη ή εάν πρέπει να αναπτυχθούν νέα λόγω μεταλλάξεων».
Ένα δείγμα που ανέλυσαν οι επιστήμονες, που χρονολογείται περίπου 5.500 χρόνια πριν, περιείχε το παλαιότερο γνωστό γενετικό ίχνος στον κόσμο, του Yersinia pestis, του βακτηρίου που προκάλεσε την πανώλη, η οποία σκότωσε μεταξύ 30 και 50% του πληθυσμού της Ευρώπης κατά τον Μεσαίωνα. Το παθογόνο εξαπλώνεται από ψύλλους σε τρωκτικά και σε ανθρώπους - ακόμη και σήμερα - και είναι μόνο ένα παράδειγμα του πώς οι ζωονόσοι έχουν ασκήσει τεράστια επιρροή στην ανθρώπινη ιστορία και τον πολιτισμό.
«Αυτές οι μολύνσεις δεν προκάλεσαν απλώς ασθένειες — μπορεί να συνέβαλαν στην κατάρρευση του πληθυσμού, τη μετανάστευση και τη γενετική προσαρμογή», προσθέτει ο Willerslev.
Ίχνη άλλων ασθενειών που εντοπίστηκαν στα ανθρώπινα οστά και δόντια περιλαμβάνουν την ελονοσία (4.200 ετών), τη λέπρα (1.400 ετών), την ηπατίτιδα Β (9.800 ετών) και τη διφθερίτιδα (11.100 ετών).
Η εργασία, αν και εκτενής, έχει μερικούς περιορισμούς, σημειώνουν οι επιστήμονες. Τα γονίδια πολλών ιών κωδικοποιούνται σε RNA, το οποίο δεν μελετήθηκε κατά τη διάρκεια αυτού του έργου. Και η έρευνα μπορεί να έχει παραβλέψει ορισμένα παθογόνα που υπήρχαν μόνο σε χαμηλά επίπεδα στα δείγματα. Επιπλέον, τα ιστορικά που αποκαλύφθηκαν περιορίζονται στις ευρασιατικές τοποθεσίες στις οποίες βρέθηκαν τα δείγματα σκελετών. Αρχαία δείγματα DNA από την Αφρική, για παράδειγμα, δεν ήταν ευρέως προσβάσιμα για αυτήν τη μελέτη, λέει ο επικεφαλής συγγραφέας Martin Sikora , γενετιστής στο Πανεπιστήμιο της Κοπεγχάγης, στους New York Times.
«Αν κατανοήσουμε τι συνέβη στο παρελθόν, αυτό μπορεί να μας βοηθήσει να προετοιμαστούμε για το μέλλον», προσθέτει η Sikora στη δήλωσή της
Πηγές:
Nature
Ειδήσεις υγείας σήμερα
Μία στις 250 καρδιές κρύβει έναν αθόρυβο κίνδυνο
Laser μυωπίας μετά τα 40: Γίνεται;
ECDC: Ενιαίες κατευθυντήριες γραμμές για πρόληψη ηπατίτιδας Β και C στην αιμοδοσία
ECDC: Ενιαίες κατευθυντήριες γραμμές για πρόληψη ηπατίτιδας Β και C στην αιμοδοσία
ECDC: Ενιαίες κατευθυντήριες γραμμές για πρόληψη ηπατίτιδας Β και C στην αιμοδοσία ECDC: Εκτός στόχων η ΕΕ στον έλεγχο φυματίωσης, ιογενούς ηπατίτιδας, σεξουαλικώς μεταδιδόμενων νοσημάτων
ECDC: Εκτός στόχων η ΕΕ στον έλεγχο φυματίωσης, ιογενούς ηπατίτιδας, σεξουαλικώς μεταδιδόμενων νοσημάτων BehinD: Πίσω από την ηπατίτιδα Β μπορεί να κρύβεται η ηπατίτιδα D
BehinD: Πίσω από την ηπατίτιδα Β μπορεί να κρύβεται η ηπατίτιδα D ECDC: Αύξηση κρουσμάτων ηπατίτιδας Α σε μία σειρά από ευρωπαϊκές χώρες
ECDC: Αύξηση κρουσμάτων ηπατίτιδας Α σε μία σειρά από ευρωπαϊκές χώρες ECDC: Μέτρα για εξάλειψη ιογενούς ηπατίτιδας στις φυλακές
ECDC: Μέτρα για εξάλειψη ιογενούς ηπατίτιδας στις φυλακές 28η Ιουλίου, Παγκόσμια Ημέρα Ιογενούς ηπατίτιδας
28η Ιουλίου, Παγκόσμια Ημέρα Ιογενούς ηπατίτιδας Laser μυωπίας μετά τα 40: Γίνεται;
Laser μυωπίας μετά τα 40: Γίνεται; Οστεοαρθρίτιδα γόνατος: Ο εμβολισμός αρτηριών μειώνει τον πόνο έως και έναν χρόνο
Οστεοαρθρίτιδα γόνατος: Ο εμβολισμός αρτηριών μειώνει τον πόνο έως και έναν χρόνο Alzheimer: Διαθέσιμη και στην Ελλάδα η πρώτη εξέταση αίματος που μπορεί να συμβάλει στον αποκλεισμό της νόσου
Alzheimer: Διαθέσιμη και στην Ελλάδα η πρώτη εξέταση αίματος που μπορεί να συμβάλει στον αποκλεισμό της νόσου Δώδεκα γιατροί και νοσηλευτές σε δίκη για τον θάνατο 27χρονου στο 424 ΓΣΝΕ
Δώδεκα γιατροί και νοσηλευτές σε δίκη για τον θάνατο 27χρονου στο 424 ΓΣΝΕ Ρύζι, πατάτες και ζυμαρικά: Ποιο είναι χειρότερο για το σάκχαρο;
Ρύζι, πατάτες και ζυμαρικά: Ποιο είναι χειρότερο για το σάκχαρο; Με ποιες τροφές να συνδυάζω ρύζι, πατάτες και ζυμαρικά για να μην αυξάνεται απότομα το σάκχαρο
Με ποιες τροφές να συνδυάζω ρύζι, πατάτες και ζυμαρικά για να μην αυξάνεται απότομα το σάκχαρο Pharmathen: Βαθιά κρίση και μηδενισμός αποτίμησης από funds της Partners
Pharmathen: Βαθιά κρίση και μηδενισμός αποτίμησης από funds της Partners Καρπούζι: Ποια είναι τα οφέλη του στην υγεία
Καρπούζι: Ποια είναι τα οφέλη του στην υγεία Ιατρικός Σύλλογος Θεσσαλονίκης: Σαρωτική επικράτηση της ΕΝΟ.ΣΥ. - Ν.Ι.Κ.Ι.
Ιατρικός Σύλλογος Θεσσαλονίκης: Σαρωτική επικράτηση της ΕΝΟ.ΣΥ. - Ν.Ι.Κ.Ι. Φαρμακοβιομηχανίες σκέφτονται να χτυπήσουν την πόρτα της Εθνικής Αρχής Διαφάνειας
Φαρμακοβιομηχανίες σκέφτονται να χτυπήσουν την πόρτα της Εθνικής Αρχής Διαφάνειας Οι απρόσμενες συνέπειες της ολοκληρωτικής παράλειψης της ζάχαρης από τη διατροφή [μελέτη]
Οι απρόσμενες συνέπειες της ολοκληρωτικής παράλειψης της ζάχαρης από τη διατροφή [μελέτη] 9 εξακριβωμένα οφέλη του κολοκυθόσπορου
9 εξακριβωμένα οφέλη του κολοκυθόσπορου